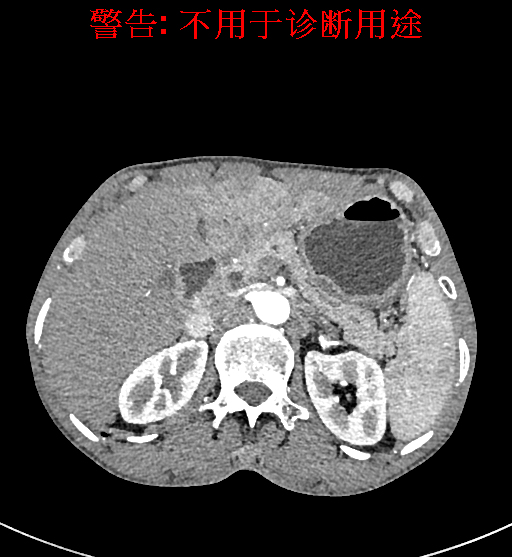

辅助检查: 上腹部CT动态增强扫描示肝内多发占位并门静脉左支瘤栓,考虑肝癌可能性大,请结合临床肝胃间隙多发肿大淋巴结左肾囊肿。
实验室检查: 血常规:WBC 4.89*109/L,RBC 3.64*1012/L, HB 119.00g/L, HCT 35.40%,PLT 123*109/L,RET% 0.48%, RET 0.017*1012/L, IRF 2.00%生化全套:ALT 56.00U/L AST 60.00U/L, LDH 312.00U/L TP 72.08g/L ALB 32.44g/L, GGT 101.00U/L,TBA 21.90umol/L,A/G 0.82,ADA 23.00U/L, PAB 94.20mg/L, CHE 5405.00U/L 肿瘤标志物:CEA 2.80ng/mL CA19-9 11.46U/ml 肝炎全套: HAV-IgM 0.21S/CO, HBcIgM 0.330S/CO, HCV-cAg 0.08S/CO, HEV-IgM 0.03S/CO, HBeAg 6.000S/CO 诊疗过程: CT结果输入海信CAS系统后行3D重建及手术规划后,于2018-5-17局麻下行“经皮肝动脉造影术+肝动脉化疗栓塞术”手术治疗 术前三维重建及手术方案设计: 将0.625mm双源薄层CT资料的静脉期和动脉期Dicom格式文件导入海信CAS系统。 通过调节窗宽窗位调整CT序号,对肿瘤,肝实质,胆囊,下腔静脉,肿瘤,肝动脉、门静脉及肝静脉等进行三维重建;系统自动计算肿瘤体积和肝脏体积。肝脏体积为1563ml,肿瘤体积为537.6ml,通过比对50-60岁正常肝脏体积为1343.28±246.69ml。 手术步骤: 常规准备后,患者仰卧于DSA手术床。常规双侧股动脉区域消毒,铺巾。2%利多卡因局部麻醉右侧股动脉区成功后,应用Seldinger技术穿刺右侧股动脉,置入5F动脉鞘。送5F 肝导管至腹腔干、肝动脉造影,肝区可见团块状及多发结节状肿瘤染色、侵犯门静脉左支。静脉推注维瑞特5mg后,透视下将微导管分别超选择至各支肿瘤供血动脉内,应用雷替曲塞4mg+奥沙利铂50mg+表柔比星20mg +LP 10ml的混合液及适量350-560um明胶海绵进行栓塞,后造影示栓塞适量,退出导管、血管鞘,局部压迫10min,加压包扎。患者术中未诉不适,术后平车安返病房。随访情况: 患者术后3月复查上腹CT示肝左叶病变活性残留,腹腔内、腹膜后多发略大淋巴结,部分较前略减小,今患者为求进一步诊治,与我院再次行“肝动脉造影+经导管肝动脉栓塞术”,术后2周无明显不适 术前CT检查:动脉期
 静脉期
静脉期
 平衡期
平衡期
 术前三维重建:重建图片
术前三维重建:重建图片.jpg)
.jpg)
.jpg)
.jpg)
.jpg)
.jpg) 重建视频
重建视频

.jpg)
.jpg)
.jpg)
.jpg)
.jpg)
.jpg)